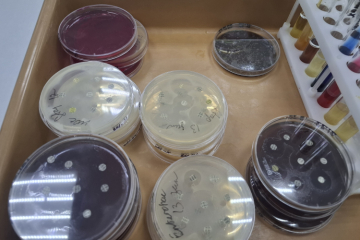
Здоровье ушей хвостатых питомцев

Новости Смотреть все
Об учреждении
Краснодарский филиал ФГБУ «ВНИИЗЖ»
Основная цель деятельности Краснодарского филиала ФГБУ "ВНИИЗЖ" - реализация единой государственной политики в области ветеринарии, карантина растений, семеноводства, агрохимии и плодородия почв, качества и безопасности зерна, комбикормов и компонентов для их производства, а также побочных продуктов переработки зерна, охраны, воспроизводства, использования объектов животного мира, отнесенных к объектам охоты, водных биологических ресурсов и среды их обитания.
Актуальная информация

 
ФЕДЕРАЛЬНАЯ ГОСУДАРСТВЕННАЯ ИНФОРМАЦИОННАЯ СИСТЕМА ПРОСЛЕЖИВАЕМОСТИ ПЕСТИЦИДОВ И АГРОХИМИКАТОВ «САТУРН»
Читать далее
 
Испытательный центр ФГБУ «Краснодарская МВЛ» расширил область аккредитации по методам испытаний пищевых продуктов на определение остаточных количеств лекарственных ветеринарных препаратов и пестицидов
Читать далее


 
Выдача протоколов испытаний для декларирования и оказание помощи в оформлении декларации соответствия. Информация по телефону: 8 (918) 068-15-84
Читать далее

Краснодарский орган инспекции
Краснодарская
испытательная лаборатория
испытательная лаборатория
Химико-токсикологический отделОтдел по работе с заказчиком и обращению с объектами исследований (пищевые пробы)Отдел по работе с заказчиком и обращению с объектами исследований (диагностический материал)Отдел бактериологии, паразитологии и питательных средОтдел серологии и биохимииОтдел вирусологии, патоморфологии и ПЦР исследованийОтдел пищевой микробиологии и ветеринарно-санитарной экспертизыСектор обеспечения лабораторными животными
Краснодарская фитосанитарная
испытательная лаборатория
испытательная лаборатория
Отдел лабораторных испытаний по карантину растенийОтдел испытаний в области карантина растений и семеноводстваЕйская лабораторияТемрюкская лабораторияТбилисская лабораторияПавловская лабораторияГулькевичская лабораторияКалининская лабораторияЛабинская лабораторияРегиональная лаборатория по Республике Адыгея